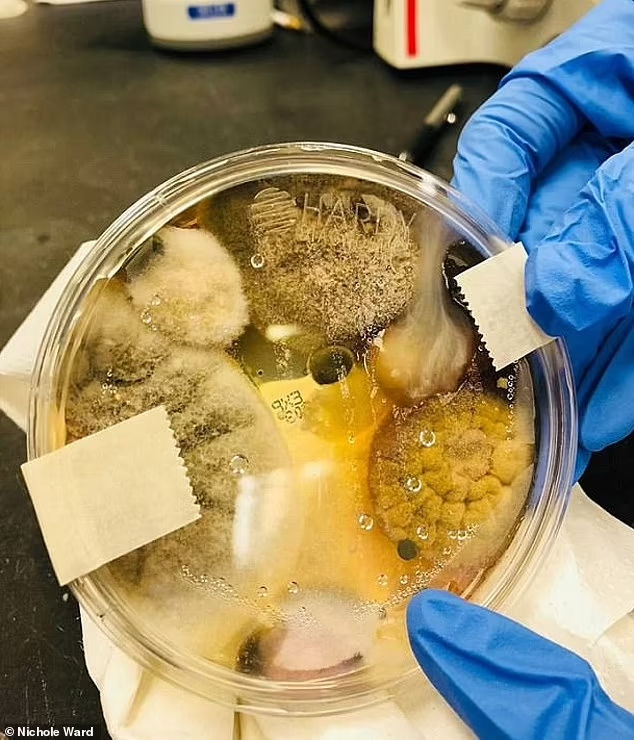
9vWUp0M4Ri9vtcJfB9EGWnfW2oPnFw9IRh_6AWh09BMeOSuy5HN5gaZafZ1m3-QOqrSg6BJ8uSdeqVgIwDZEMuoKIWZfsHz08p3rB_gKCV7635WmKiYiAO4S638CKs5qJZQtnovCwgyIvch5JoHiiQ

Shocking experiment shows why you should NEVER use a bathroom hand dryer
By
- Replies 6
Sanitising your hands is one of the best ways to protect yourself and others from getting sick, especially in light of the continued serious global dangers posed by COVID-19.
If you're anything like us, you're constantly washing your hands and using hand sanitisers to keep them clean. However, there are times when you just can't get to a sink or you're out and about and don't have any hand sanitiser with you.
Fortunately for us, there are plenty of public toilets that give us access to clean water and soap and allow us to wash our hands whenever the need arises.
But while hand dryers in public toilets may offer a quick and convenient way to dry your hands after washing, did you know that experts actually advise against using them?
You read that right, folks! We were stunned to find out that health experts are actively informing the public about the potential risks of using hand dryers to dry your hands.
In a recent TikTok video shared by US company Phone Soap, a man illustrated how many more germs can develop on your hands after using a hand dryer as opposed to just shaking them dry.
Credit: TikTok/Phone Soap
The man was seen using several petri dishes at different locations to test out the two "hand drying" techniques, simulating the ways we can inadvertently acquire bacteria and germs after washing our hands.
The petri dishes were then kept in an incubator for three days before they were examined for microbe growth.
The results of the experiment? The petri dishes that were "dried" using a hand dryer grew cultures of germs and bacteria while the ones that were shaken off were free from any microbes.
The post captured the attention of social media users, including World Health Organisation COVID-19 mortality epidemiologist Dr Eric Feigl-Ding who reposted the video on his Twitter page.
"Nota Bene—DO NOT USE BATHROOM HAND DRYERS. Research shows these dryers suck in and blow fecal aerosols. Shake your hands dry instead," the expert wrote.
It comes after a California woman shared a frightening image of a petri dish full of what she claims are "possibly deadly bacteria and fungi that can be blown onto your skin every time you use an enclosed hand dryer" on social media, warning people to beware of them.
Credit: Facebook/Nichole Ward
Nichole Ward, who took to Facebook to share the unsettling findings of the experiment, said that the infected petri dish was placed in a hand dryer for three minutes before it was incubated for 48 hours and was examined.
She explained that when individuals use enclosed hand dryers, they come into contact with "many strains of potentially harmful fungus and bacteria".
Pathogenic fungi and bacteria are the types of microorganisms that cause diseases, Ms Ward noted.
She said: "I stuck the open plate in an enclosed hand dryer of a public bathroom for a total of 3 minutes. Yes, 3 only. "
"DO NOT EVER dry your hands in those things again."
She then advised people to just shake their hands dry or use a paper towel after washing, noting that it is best to dry your hands after sanitising as bacteria can easily be transferred when they are moist.
So, there you have it, folks! As advised by experts, we suggest keeping a small packet of tissues along with your hand sanitiser whenever you feel the need to sanitise your hands in order to better protect yourself from health risks. Stay safe out there!
Also, we understand that there have been a lot of scientific terms and processes discussed in this article, so to help you understand them further, we recommend checking out this illustrated explainer video:
Credit: YouTube/The Infographics Show
If you're anything like us, you're constantly washing your hands and using hand sanitisers to keep them clean. However, there are times when you just can't get to a sink or you're out and about and don't have any hand sanitiser with you.
Fortunately for us, there are plenty of public toilets that give us access to clean water and soap and allow us to wash our hands whenever the need arises.
But while hand dryers in public toilets may offer a quick and convenient way to dry your hands after washing, did you know that experts actually advise against using them?
You read that right, folks! We were stunned to find out that health experts are actively informing the public about the potential risks of using hand dryers to dry your hands.
In a recent TikTok video shared by US company Phone Soap, a man illustrated how many more germs can develop on your hands after using a hand dryer as opposed to just shaking them dry.
Credit: TikTok/Phone Soap
The man was seen using several petri dishes at different locations to test out the two "hand drying" techniques, simulating the ways we can inadvertently acquire bacteria and germs after washing our hands.
The petri dishes were then kept in an incubator for three days before they were examined for microbe growth.
The results of the experiment? The petri dishes that were "dried" using a hand dryer grew cultures of germs and bacteria while the ones that were shaken off were free from any microbes.
The post captured the attention of social media users, including World Health Organisation COVID-19 mortality epidemiologist Dr Eric Feigl-Ding who reposted the video on his Twitter page.
"Nota Bene—DO NOT USE BATHROOM HAND DRYERS. Research shows these dryers suck in and blow fecal aerosols. Shake your hands dry instead," the expert wrote.
It comes after a California woman shared a frightening image of a petri dish full of what she claims are "possibly deadly bacteria and fungi that can be blown onto your skin every time you use an enclosed hand dryer" on social media, warning people to beware of them.
Credit: Facebook/Nichole Ward
Nichole Ward, who took to Facebook to share the unsettling findings of the experiment, said that the infected petri dish was placed in a hand dryer for three minutes before it was incubated for 48 hours and was examined.
She explained that when individuals use enclosed hand dryers, they come into contact with "many strains of potentially harmful fungus and bacteria".
Pathogenic fungi and bacteria are the types of microorganisms that cause diseases, Ms Ward noted.
She said: "I stuck the open plate in an enclosed hand dryer of a public bathroom for a total of 3 minutes. Yes, 3 only. "
"DO NOT EVER dry your hands in those things again."
She then advised people to just shake their hands dry or use a paper towel after washing, noting that it is best to dry your hands after sanitising as bacteria can easily be transferred when they are moist.
So, there you have it, folks! As advised by experts, we suggest keeping a small packet of tissues along with your hand sanitiser whenever you feel the need to sanitise your hands in order to better protect yourself from health risks. Stay safe out there!
Also, we understand that there have been a lot of scientific terms and processes discussed in this article, so to help you understand them further, we recommend checking out this illustrated explainer video:
Credit: YouTube/The Infographics Show







